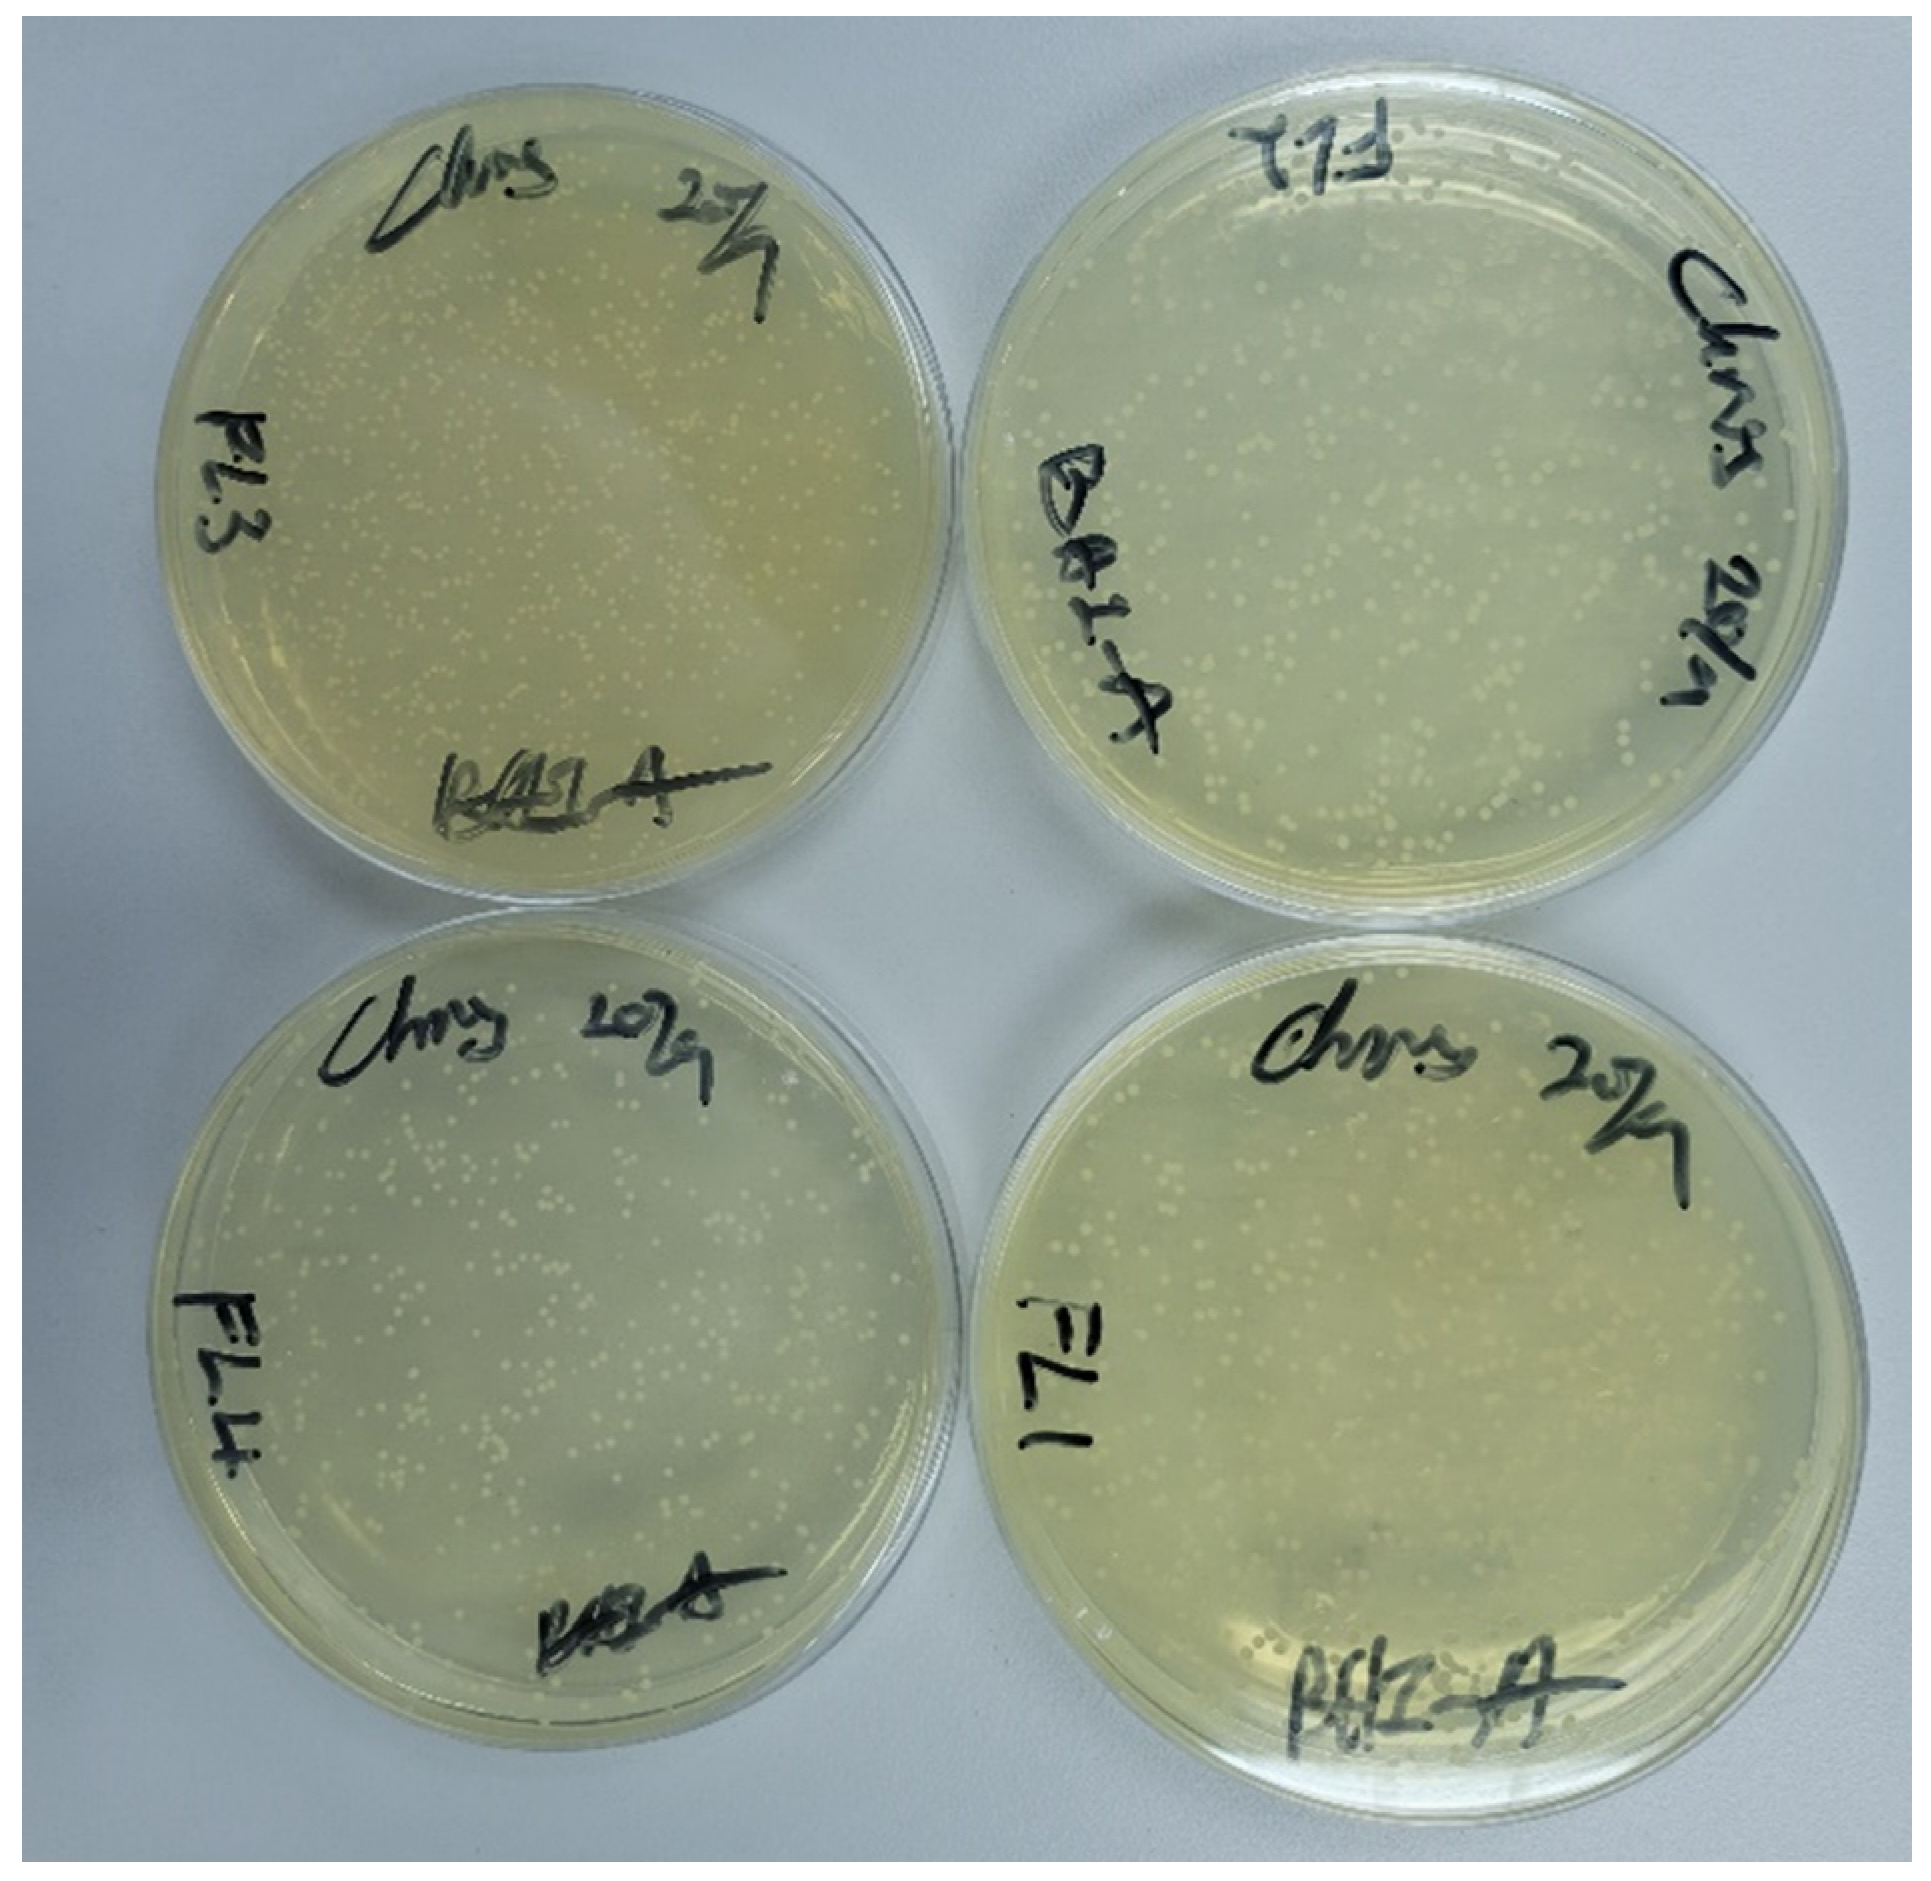
Polymers 15 01463 g005 Polymers 15 01463 g005

Effect of Different Vat Polymerization Techniques on Mechanical and Biological Properties of 3D-Printed Denture Base
Abstract
1. Introduction
2. Materials and Methods
2.1. Specimens’ Preparation
2.2. Flexural Strength and Modulus
2.3. Fracture Toughness
2.4. Water Sorption and Solubility
2.5. Fungus Adhesion
2.6. Statistical Analysis
3. Results
3.1. Flexural Strength and Modulus
3.2. Fracture Toughness
3.3. Water Sorption and Solubility
3.4. Fungal Adhesion
4. Discussion
5. Conclusions
Author Contributions
Funding
Institutional Review Board Statement
Data Availability Statement
Conflicts of Interest
References
- Cunha-Cruz, J.; Hujoel, P.P.; Nadanovsky, P. Nadanovsky Secular Trends in Socio-Economic Disparities in Edentulism. J. Dent. Res. 2007, 86, 131–136. [Google Scholar] [CrossRef]
- Altarazi, A.; Haider, J.; Alhotan, A.; Silikas, N.; Devlin, H. Assessing the Physical and Mechanical Properties of 3D Printed Acrylic Material for Denture Base Application. Dent. Mater. 2022, 38, 1841–1854. [Google Scholar] [CrossRef]
- Florina Andreescu, C.; Lucia Ghergic, D.; Botoaca, O.; Hancu, V.; Mariana Banateanu, A.; Nicolae Patroi, D. Evaluation of Different Materials Used for Fabrication of Complete Digital Denture. Mater. Plast. 2018, 55, 124–128. [Google Scholar] [CrossRef]
- Srinivasan, M.; Kalberer, N.; Kamnoedboon, P.; Mekki, M.; Durual, S.; Özcan, M.; Müller, F. CAD-CAM Complete Denture Resins: An Evaluation of Biocompatibility, Mechanical Properties, and Surface Characteristics. J. Dent. 2021, 114, 103785. [Google Scholar] [CrossRef]
- Soygun, K.; Bolayir, G.; Boztug, A. Mechanical and Thermal Properties of Polyamide versus Reinforced PMMA Denture Base Materials. J. Adv. Prosthodont. 2013, 5, 153–160. [Google Scholar] [CrossRef]
- Rashid, H.; Sheikh, Z.; Vohra, F. Allergic Effects of the Residual Monomer Used in Denture Base Acrylic Resins. Eur. J. Dent. 2015, 9, 614–619. [Google Scholar] [CrossRef]
- Einarsdottir, E.R.; Geminiani, A.; Chochlidakis, K.; Feng, C.; Tsigarida, A.; Ercoli, C. Dimensional Stability of Double-Processed Complete Denture Bases Fabricated with Compression Molding, Injection Molding, and CAD-CAM Subtraction Milling. J. Prosthet. Dent. 2020, 124, 116–121. [Google Scholar] [CrossRef]
- Anadioti, E.; Musharbash, L.; Blatz, M.B.; Papavasiliou, G.; Kamposiora, P. 3D Printed Complete Removable Dental Prostheses: A Narrative Review. BMC Oral Health 2020, 20, 343. [Google Scholar] [CrossRef]
- Alauddin, M.S.; Baharuddin, A.S.; Ghazali, M.I.M. The Modern and Digital Transformation of Oral Health Care: A Mini Review. Healthcare 2021, 9, 118. [Google Scholar] [CrossRef]
- Alauddin, M.S. A Review of Polymer Crown Materials: Biomechanical and Material Science. J. Clin. Diagn. Res. 2019, 13, ZE01–ZE05. [Google Scholar] [CrossRef]
- di Fiore, A.; Meneghello, R.; Brun, P.; Rosso, S.; Gattazzo, A.; Stellini, E.; Yilmaz, B. Comparison of the Flexural and Surface Properties of Milled, 3D-Printed, and Heat Polymerized PMMA Resins for Denture Bases: An in Vitro Study. J. Prosthodont. Res. 2022, 66, 502–508. [Google Scholar] [CrossRef]
- Gad, M.M.; Fouda, S.M.; Abualsaud, R.; Alshahrani, F.A.; Al-Thobity, A.M.; Khan, S.Q.; Akhtar, S.; Ateeq, I.S.; Helal, M.A.; Al-Harbi, F.A. Strength and Surface Properties of a 3D-Printed Denture Base Polymer. J. Prosthodont. 2022, 31, 412–418. [Google Scholar] [CrossRef] [PubMed]
- Chhabra, M.; Nanditha Kumar, M.; RaghavendraSwamy, K.N.; Thippeswamy, H.M. Flexural Strength and Impact Strength of Heat-Cured Acrylic and 3D Printed Denture Base Resins- A Comparative in Vitro Study. J. Oral Biol. Craniofac. Res. 2022, 12, 1–3. [Google Scholar] [CrossRef] [PubMed]
- Li, P.; Fernandez, P.K.; Spintzyk, S.; Schmidt, F.; Beuer, F.; Unkovskiy, A. Effect of Additive Manufacturing Method and Build Angle on Surface Characteristics and Candida Albicans Adhesion to 3D Printed Denture Base Polymers. J. Dent. 2022, 116, 103889. [Google Scholar] [CrossRef]
- Puškar, T.; Trifković, B.; Koprivica, D.D.; Kojić, V.; Jevremović, A.; Mirković, S.; Eggbeer, D. In Vitro Cytotoxicity Assessment of the 3D Printed Polymer Based Epoxy Resin Intended for Use in Dentistry. Vojnosanit. Pregl. 2019, 76, 502–509. [Google Scholar] [CrossRef]
- Aati, S.; Akram, Z.; Shrestha, B.; Patel, J.; Shih, B.; Shearston, K.; Ngo, H.; Fawzy, A. Effect of Post-Curing Light Exposure Time on the Physico–Mechanical Properties and Cytotoxicity of 3D-Printed Denture Base Material. Dent. Mater. 2022, 38, 57–67. [Google Scholar] [CrossRef]
- Jockusch, J.; Özcan, M. Additive Manufacturing of Dental Polymers: An Overview on Processes, Materials and Applications. Dent. Mater. J. 2020, 39, 345–354. [Google Scholar] [CrossRef]
- Unkovskiy, A.; Schmidt, F.; Beuer, F.; Li, P.; Spintzyk, S.; Fernandez, P.K. Stereolithography vs. Direct Light Processing for Rapid Manufacturing of Complete Denture Bases: An in Vitro Accuracy Analysis. J. Clin. Med. 2021, 10, 1070. [Google Scholar] [CrossRef]
- Quan, H.; Zhang, T.; Xu, H.; Luo, S.; Nie, J.; Zhu, X. Photo-Curing 3D Printing Technique and Its Challenges. Bioact. Mater. 2020, 5, 110–115. [Google Scholar] [CrossRef]
- Zhu, Y.; Ramadani, E.; Egap, E. Thiol Ligand Capped Quantum Dot as an Efficient and Oxygen Tolerance Photoinitiator for Aqueous Phase Radical Polymerization and 3D Printing under Visible Light. Polym. Chem. 2021, 12, 5106–5116. [Google Scholar] [CrossRef]
- Wang, G.; Hill, N.S.; Zhu, D.; Xiao, P.; Coote, M.L.; Stenzel, M.H. Efficient Photoinitiating System Based on Diaminoanthraquinone for 3D Printing of Polymer/Carbon Nanotube Nanocomposites under Visible Light. ACS Appl. Polym. Mater. 2019, 1, 1129–1135. [Google Scholar] [CrossRef]
- Kim, D.; Shim, J.S.; Lee, D.; Shin, S.H.; Nam, N.E.; Park, K.H.; Shim, J.S.; Kim, J.E. Effects of Post-Curing Time on the Mechanical and Color Properties of Three-Dimensional Printed Crown and Bridge Materials. Polymers 2020, 12, 2762. [Google Scholar] [CrossRef] [PubMed]
- Chen, H.; Cheng, D.H.; Huang, S.C.; Lin, Y.M. Comparison of Flexural Properties and Cytotoxicity of Interim Materials Printed from Mono-LCD and DLP 3D Printers. J. Prosthet. Dent. 2021, 126, 703–708. [Google Scholar] [CrossRef]
- Cristache, C.M.; Totu, E.E.; Iorgulescu, G.; Pantazi, A.; Dorobantu, D.; Nechifor, A.C.; Isildak, I.; Burlibasa, M.; Nechifor, G.; Enachescu, M. Eighteen Months Follow-up with Patient-Centered Outcomes Assessment of Complete Dentures Manufactured Using a Hybrid Nanocomposite and Additive CAD/CAM Protocol. J. Clin. Med. 2020, 9, 324. [Google Scholar] [CrossRef] [PubMed]
- Waheed, S.; Cabot, J.M.; Macdonald, N.P.; Lewis, T.; Guijt, R.M.; Paull, B.; Breadmore, M.C. 3D Printed Microfluidic Devices: Enablers and Barriers. Lab. Chip 2016, 16, 1993–2013. [Google Scholar] [CrossRef] [PubMed]
- Koch Scotti, C.; Mattar, M.; Campos Velo, A.; Antonio, F.; Rizzante, P.; Rita De Lima Nascimento, T.; Francisco, R.; Mondelli, L.; Fraga, J.; Bombonatti, S. Physical and Surface Properties of a 3D-Printed Composite Resin for a Digital Workflow. J. Prosthet. Dent. 2020, 124, 614.e1–614.e5. [Google Scholar]
- Dizon, J.R.C.; Espera, A.H.; Chen, Q.; Advincula, R.C. Mechanical Characterization of 3D-Printed Polymers. Addit. Manuf. 2018, 20, 44–67. [Google Scholar] [CrossRef]
- Chang, D.G.; Li, S.M.; An, C.F. The Influence Analysis of Globular Indexing Cam Mechanism Size Parameters on Transmission Performance. Adv. Mater. Res. 2012, 426, 163–167. [Google Scholar] [CrossRef]
- Shan, W.; Chen, Y.; Hu, M.; Qin, S.; Liu, P. 4D Printing of Shape Memory Polymer via Liquid Crystal Display (LCD) Stereolithographic 3D Printing. Mater. Res. Express 2020, 7, 105305. [Google Scholar] [CrossRef]
- Mohamed, M.G.A.; Kumar, H.; Wang, Z.; Martin, N.; Mills, B.; Kim, K. Rapid and Inexpensive Fabrication of Multi-Depth Microfluidic Device Using High-Resolution LCD Stereolithographic 3D Printing. J. Manuf. Mater. Process. 2019, 3, 26. [Google Scholar] [CrossRef]
- Wang, C.; Shi, Y.-F.; Xie, P.-J.; Wu, J.-H. Accuracy of Digital Complete Dentures: A Systematic Review of in Vitro Studies. J. Prosthet. Dent. 2021, 125, 249–256. [Google Scholar] [CrossRef] [PubMed]
- Zhang, Z.-C.; Li, P.-L.; Chu, F.-T.; Shen, G. Influence of the Three-Dimensional Printing Technique and Printing Layer Thickness on Model Accuracy. J. Orofac. Orthop. 2019, 80, 194–204. [Google Scholar] [CrossRef] [PubMed]
- Al-Qarni, F.D.; Gad, M.M. Printing Accuracy and Flexural Properties of Different 3D-Printed Denture Base Resins. Materials 2022, 15, 2410. [Google Scholar] [CrossRef]
- Zinelis, S.; Panayi, N.; Polychronis, G.; Papageorgiou, S.N.; Eliades, T. Comparative Analysis of Mechanical Properties of Orthodontic Aligners Produced by Different Contemporary 3D Printers. Orthod. Craniofac. Res. 2022, 25, 336–341. [Google Scholar] [CrossRef] [PubMed]
- Al-Dulaijan, Y.A.; Alsulaimi, L.; Alotaibi, R.; Alboainain, A.; Alalawi, H.; Alshehri, S.; Khan, S.Q.; Alsaloum, M.; AlRumaih, H.S.; Alhumaidan, A.A.; et al. Comparative Evaluation of Surface Roughness and Hardness of 3D Printed Resins. Materials 2022, 15, 6822. [Google Scholar] [CrossRef]
- ISO 20795-1; Dentistry-Base Polymers-Part 1: Denture Base Polymers. 2nd ed. International Organization for Standardization: Geneva, Switzerland, 2013.
- Thomas, P.; Sekhar, A.C.; Upreti, R.; Mujawar, M.M.; Pasha, S.S. Optimization of Single Plate-Serial Dilution Spotting (SP-SDS) with Sample Anchoring as an Assured Method for Bacterial and Yeast Cfu Enumeration and Single Colony Isolation from Diverse Samples. Biotechnol. Rep. 2015, 8, 45–55. [Google Scholar] [CrossRef]
- ISO 10993-5: 2009; Biological Evaluation of Medical Devices—Part 5: Tests for In Vitro Cytotoxicity. International Organization for Standardization: Geneva, Switzerland, 2009.
- ISO 10993-12: 2012; Biological Evaluation of Medical Devices—Part 12: Sample Preparation and Reference Materials. International Organization for Standardization: Geneva, Switzerland, 2012.
- Han, Z.; Liu, W.; Sun, Y.; Zhou, Q.; Zhao, Y.; Sun, J.; Zhu, B.; Yu, Y. Antimicrobial Properties, Cytotoxicity, Colour and Mechanical Behavior of Light-Cured Resin Composites Containing Modified Novaron. PeerJ Mater. Sci. 2022, 4, e19. [Google Scholar] [CrossRef]
- Zupancic Cepic, L.; Dvorak, G.; Piehslinger, E.; Georgopoulos, A. In Vitro Adherence of Candida Albicans to Zirconia Surfaces. Oral Dis. 2020, 26, 1072–1080. [Google Scholar] [CrossRef] [PubMed]
- Sampaio-Maia, B.; Figueiral, M.H.; Sousa-Rodrigues, P.; Fernandes, M.H.; Scully, C. The Effect of Denture Adhesives on Candida Albicans Growth in Vitro. Gerodontology 2012, 29, e348–e356. [Google Scholar] [CrossRef]
- Ben-David, A.; Davidson, C.E. Estimation Method for Serial Dilution Experiments. J. Microbiol. Methods 2014, 107, 214–221. [Google Scholar] [CrossRef]
- John, J.; Gangadhar, S.A.; Shah, I. Flexural Strength of Heat-Polymerized Polymethyl Methacrylate Denture Resin Reinforced with Glass, Aramid, or Nylon Fibers. J. Prosthet. Dent. 2001, 86, 424–427. [Google Scholar] [CrossRef] [PubMed]
- Li, B.B.; Bin Xu, J.; Cui, H.Y.; Lin, Y.; Di, P. In Vitro Evaluation of the Flexural Properties of All-on-Four Provisional Fixed Denture Base Resin Partially Reinforced with Fibers. Dent. Mater. J. 2016, 35, 264–269. [Google Scholar] [CrossRef]
- Shim, J.S.; Kim, J.E.; Jeong, S.H.; Choi, Y.J.; Ryu, J.J. Printing Accuracy, Mechanical Properties, Surface Characteristics, and Microbial Adhesion of 3D-Printed Resins with Various Printing Orientations. J. Prosthet. Dent. 2020, 124, 468–475. [Google Scholar] [CrossRef]
- Perea-Lowery, L.; Gibreel, M.; Vallittu, P.K.; Lassila, L.V. 3d-Printed vs. Heat-Polymerizing and Autopolymerizing Denture Base Acrylic Resins. Materials 2021, 14, 5781. [Google Scholar] [CrossRef]
- Perea-Lowery, L.; Gibreel, M.; Vallittu, P.K.; Lassila, L. Evaluation of the Mechanical Properties and Degree of Conversion of 3D Printed Splint Material. J. Mech. Behav. Biomed. Mater. 2021, 115, 104254. [Google Scholar] [CrossRef]
- Kim, S.-H.; Watts, D.C. Degree of Conversion of Bis-Acrylic Based Provisional Crown and Fixed Partial Denture Materials. J. Korean Acad. Prosthodont. 2008, 46, 639–643. [Google Scholar] [CrossRef]
- Bartoloni, J.A.; Murchison, D.F.; Wofford, D.T.; Sarkar, N.K. Degree of Conversion in Denture Base Materials for Varied Polymerization Techniques. J. Oral Rehabil. 2000, 27, 488–493. [Google Scholar] [CrossRef]
- Reymus, M.; Lümkemann, N.; Stawarczyk, B. 3D-Printed Material for Temporary Restorations: Impact of Print Layer Thickness and Post-Curing Method on Degree of Conversion. Int. J. Comput. Dent. 2019, 22, 231–237. [Google Scholar]
- Li, P.; Lambart, A.L.; Stawarczyk, B.; Reymus, M.; Spintzyk, S. Postpolymerization of a 3D-Printed Denture Base Polymer: Impact of Post-Curing Methods on Surface Characteristics, Flexural Strength, and Cytotoxicity. J. Dent. 2021, 115, 3856. [Google Scholar] [CrossRef]
- Brading Bebington, M.G.; D Marsh Salisbury, U.P. The Oral Environment: The Challenge for Antimicrobials in Oral Care Products. Int. Dent. J. 2003, 53, 353–362. [Google Scholar] [CrossRef]
- Dhir, G.; Berzins, D.W.; Dhuru, V.B.; Periathamby, A.R.; Dentino, A. Physical Properties of Denture Base Resins Potentially Resistant to Candida Adhesion. J. Prosthodont. 2007, 16, 465–472. [Google Scholar] [CrossRef]
- Zidan, S.; Silikas, N.; Haider, J.; Yates, J. Long-Term Sorption and Solubility of Zirconia-Impregnated PMMA Nanocomposite in Water and Artificial Saliva. Materials 2020, 13, 3732. [Google Scholar] [CrossRef] [PubMed]
- Nguyen, L.G.; Kopperud, H.M.; Øilo, M. Water Sorption and Solubility of Polyamide Denture Base Materials. Acta Biomater. Odontol. Scand. 2017, 3, 47–52. [Google Scholar] [CrossRef] [PubMed]
- Gad, M.M.; Alshehri, S.Z.; Alhamid, S.A.; Albarrak, A.; Khan, S.Q.; Alshahrani, F.A.; Alqarawi, F.K. Water Sorption, Solubility, and Translucency of 3D-Printed Denture Base Resins. Dent. J. 2022, 10, 42. [Google Scholar] [CrossRef] [PubMed]
- Lassila LV, J.; Vallittu, P.K. Denture Base Polymer Alldent Sinomer: Mechanical Properties, Water Sorption and Release of Residual Compounds. J. Oral Rehabil. 2001, 28, 607–613. [Google Scholar] [CrossRef]
- Greil, V.; Mayinger, F.; Reymus, M.; Stawarczyk, B. Water Sorption, Water Solubility, Degree of Conversion, Elastic Indentation Modulus, Edge Chipping Resistance and Flexural Strength of 3D-Printed Denture Base Resins. J. Mech. Behav. Biomed. Mater. 2023, 137, 105565. [Google Scholar] [CrossRef]
- Hirasawa, M.; Tsutsumi-Arai, C.; Takakusaki, K.; Oya, T.; Fueki, K.; Wakabayashi, N. Superhydrophilic Co-Polymer Coatings on Denture Surfaces Reduce Candida Albicans Adhesion—An in Vitro Study. Arch. Oral Biol. 2018, 87, 143–150. [Google Scholar] [CrossRef]
- Barone, S.; Neri, P.; Paoli, A.; Razionale, A.V.; Tamburrino, F. Development of a DLP 3D Printer for Orthodontic Applications. Proc. Procedia Manuf. 2019, 38, 1017–1025. [Google Scholar] [CrossRef]
- Jung, G.K. In Vitro Analysis of Attachment of Candida Albicans to Denture Base Acrylic Resins Fabricated by Three Different Methods. Ph.D. Thesis, Uniformed Services University of the Health Sciences, Bethesda, MA, USA, 2020. [Google Scholar]
- Koujan, A.; Aggarwal, H.; Chen, P.H.; Li, Z.; Givan, D.A.; Zhang, P.; Fu, C.C. Evaluation of Candida Albicans Adherence to CAD-CAM Milled, 3D-Printed, and Heat-Cured PMMA Resin and Efficacy of Different Disinfection Techniques: An In Vitro Study. J. Prosthodont. 2022; Early View. [Google Scholar] [CrossRef]

| SLA | DLP | LCD |
|---|---|---|
![]() | ![]() | ![]() |
| Cross-sectional layer is cured line by line | Entire cross-sectional layer is cured at once | Entire cross-sectional layer is cured at once |
| Decent precision | High precision | Mediocre precision |
| Scalable build volume | Limited build volume | Mediocre build volume |
| Low print rate | Fast print rate | Mediocre print rate |
| Printing Technique | 3D Printer | Abbreviation | Manufacturer |
|---|---|---|---|
| Digital Light Processing | NextDent 5100 | DLP | NextDent B.V., Soesterberg, The Netherlands |
| Liquid-Crystal Display | Mono 4K | LCD | Shenzhen Anycubic Technology Co., Ltd. Shenzhen, China |
| Stereolithography | Form 2 | SLA | Formlabs Inc., Somerville, MA, USA |
| Group | Layer Thickness | Wavelength || Light Intensity | Post-Washing Solution | Post-Washing Duration | Post-Curing Station | Post-Curing Duration |
|---|---|---|---|---|---|---|
| DLP | 50 microns | 405 nm || 1.4 mW/cm2 | Ultrasonicate in 99.9% IPA | 5 min | LC-D Print Box (3D systems) | 30 min |
| LCD | 50 microns | 405 nm || 1.09 mW/cm2 | Ultrasonicate in 99.9% IPA | 5 min | LC-D Print Box (3D systems) | 30 min |
| SLA | 50 microns | 405 nm || 1.176 mW/cm2 | Ultrasonicate in 99.9% IPA | 5 min | LC-D Print Box (3D systems) | 30 min |
| Characterization | NextDent 5100 (DLP) | Formlabs Form2 (SLA) | Anycubic Mono 4K (LCD) | ANOVA |
|---|---|---|---|---|
| Mean ± (SD) | Mean ± (SD) | Mean ± (SD) | F- and p-Value | |
| Flexural Strength (MPa) | 133.39 (12.66) b | 150.68 (7.93) a | 133.28 (9.39) b | F = 9.664 |
| p = 0.001 * | ||||
| Flexural Modulus (GPa) | 2.127 (0.186) b | 2.264 (0.237) b | 2.118 (0.224) b | F = 1.433 |
| p = 0.256 | ||||
| Fracture Toughness (MPa/m2) | 1.51(0.115) ab | 1.583(0.054) a | 1.464(0.049) b | F = 5.243 |
| p = 0.013 * | ||||
| Water Sorption (μg/mm3) | 31.51 (0.92) b | 27.7 (0.40) a | 28.46 (0.38) a | F = 35.021 |
| p = 0.000 * | ||||
| Water Solubility (μg/mm3) | 5.32 (0.61) b | 3.03 (0.49) a | 3.2 (1.00) a | F = 15.091 |
| p = 0.001 * | ||||
| C. Albicans Adhesion (CFU/mL) | 131.61 (48.38) a | 221.94 (65.80) b | 167.89 (83.10) ab | F = 4.109 |
| p = 0.029 * |
Disclaimer/Publisher’s Note: The statements, opinions and data contained in all publications are solely those of the individual author(s) and contributor(s) and not of MDPI and/or the editor(s). MDPI and/or the editor(s) disclaim responsibility for any injury to people or property resulting from any ideas, methods, instructions or products referred to in the content. |
© 2023 by the authors. Licensee MDPI, Basel, Switzerland. This article is an open access article distributed under the terms and conditions of the Creative Commons Attribution (CC BY) license (https://creativecommons.org/licenses/by/4.0/).
Share and Cite
Lee, H.-E.; Alauddin, M.S.; Mohd Ghazali, M.I.; Said, Z.; Mohamad Zol, S. Effect of Different Vat Polymerization Techniques on Mechanical and Biological Properties of 3D-Printed Denture Base. Polymers 2023, 15, 1463. https://doi.org/10.3390/polym15061463
Lee H-E, Alauddin MS, Mohd Ghazali MI, Said Z, Mohamad Zol S. Effect of Different Vat Polymerization Techniques on Mechanical and Biological Properties of 3D-Printed Denture Base. Polymers. 2023; 15(6):1463. https://doi.org/10.3390/polym15061463
Chicago/Turabian StyleLee, Hao-Ern, Muhammad Syafiq Alauddin, Mohd Ifwat Mohd Ghazali, Zulfahmi Said, and Syazwani Mohamad Zol. 2023. "Effect of Different Vat Polymerization Techniques on Mechanical and Biological Properties of 3D-Printed Denture Base" Polymers 15, no. 6: 1463. https://doi.org/10.3390/polym15061463
APA StyleLee, H.-E., Alauddin, M. S., Mohd Ghazali, M. I., Said, Z., & Mohamad Zol, S. (2023). Effect of Different Vat Polymerization Techniques on Mechanical and Biological Properties of 3D-Printed Denture Base. Polymers, 15(6), 1463. https://doi.org/10.3390/polym15061463




